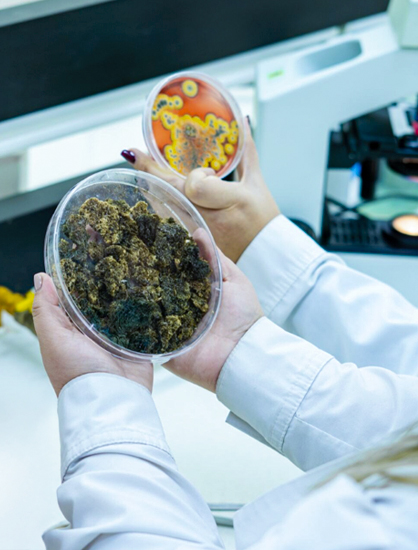

Reproducen comunidades microbianas de ecosistemas extremos
Investigan cómo recuperar suelos erosionados a través de costras microbianas
Mitigación del cambio climático
Trabajamos para mejorar suelos deteriorados
Académica y estudiantes de Bioquímica de la Universidad presentaron su proyecto en la COP30.

Costras microbianas
Fueron recolectadas en ecosistemas extremos como el desierto de Atacama y la Antártica.

Biocrust-X
La iniciativa en etapa de laboratorio podría ser una solución para mejorar suelos dañados en todo el mundo.

Seguridad alimentaria
Este tipo de proyecto aporta a aumentar la seguridad alimentaria ya que permite el mejoramiento del suelo.

Presentación en la COP30
Académica y estudiantes expusieron su investigación en la Conferencia de Partes realizada en Belem, Brasil.
Valorización de costras microbianas
Conoce la investigación que puede aportar a la agricultura del futuro
El estudio considera el uso de estas costras recolectadas en el Desierto de Atacama y la Antártica.
Innovador proyecto que busca mejorar la agricultura y a la vez aportar a la seguridad alimentaria del futuro.
El cambio climático es uno de los factores que ha generado la degradación de suelos a nivel mundial.
UTalca en la cop30
Investigación busca recuperar suelos degradados
«El proyecto fue seleccionado en el concurso “Embajadores UTalca por el cambio climático” que permitió que un equipo de la Casa de Estudios participe como parte de la delegación chilena en la COP30, que este año se realizó en la ciudad amazónica de Belém, Brasil».
En suelos agrietados y pobres en nutrientes, donde hoy cuesta que crezca la vida, un grupo de investigadores de la Universidad de Talca encontró una solución inesperada: comunidades de microorganismos que funcionan como una capa protectora que permite regenerar la tierra y “revivir” los suelos dañados por la erosión.
Se trata de un innovador proyecto que busca mejorar la agricultura y a la vez aportar a la seguridad alimentaria del futuro, y que, gracias a un concurso de la Universidad de Talca, participó en la COP30 (Conferencia de las Partes), que se desarrolla durante el mes de noviembre en Belém, Brasil.
El equipo utalino que asistió a la Conferencia y que fue parte de la Delegación chilena en esa cumbre, estuvo conformado por los estudiantes de Bioquímica Camila Castro y Francisco Escobar, quienes, junto a la académica del Departamento de Microbiología de la Universidad, Andrea Barrera Valenzuela, presentaron BIOCRUST-X, una iniciativa que propone el diseño de costras biológicas artificiales, inspiradas en ecosistemas extremos como la Antártica y el desierto de Atacama, que tienen la capacidad de mejorar la fertilidad del suelo y aumentar su retención de agua.
“Estas comunidades microbianas pueden ser una especie de cubierta natural que actúe como fertilizante. La literatura las describe como verdaderos ingenieros ecosistémicos por todas las propiedades que generan en los suelos. No solo mejoran los nutrientes, sino que también pueden incrementar sobre un 30% los niveles de agua”, explicó la profesora Barrera.
De acuerdo con información de la ONU, más del 40% de los suelos del planeta están deteriorados, comprometiendo la seguridad alimentaria y el equilibrio ecológico. La investigadora advirtió que Chile no está ajeno a esta crisis, ya que el 48,7% del territorio nacional presenta algún grado de erosión, con 18,1 millones de hectáreas clasificadas como severas o muy severas. “Con el cambio climático esa cifra podría aumentar en los próximos años. Si lo proyectamos al 2050, con una población mundial cercana a los 9.800 millones, la seguridad alimentaria se convierte en un gran desafío”, advirtió.
La académica subrayó que las consecuencias incluyen pérdida de fertilidad, salinización, escasez hídrica, disminución de la productividad agrícola y pérdida de biodiversidad, lo que afecta tanto al ecosistema como al bienestar de las comunidades rurales.
“Sabemos que las aplicaciones químicas son un gran problema, hay un gran desgaste en nuestros suelos, y eso nos impulsa a tomar nuevas iniciativas como el uso de microorganismos. Es una solución a largo plazo que da alternativas a los problemas que generan las aplicaciones químicas que ocupan diariamente los agricultores”, añadió Francisco Escobar, integrante del equipo.
Delegación en Belém
“Embajadores UTalca por el Cambio Climático” es un concurso interno de la Universidad de Talca, que tuvo su primera edición en 2024, y permitió que el equipo ganador fuese parte de la delegación nacional que viajó a la COP29 desarrollada en Bakú, Azerbaiyán, para presentar una investigación que utiliza la nanotecnología para degradar la contaminación del agua.
“Este concurso nos posiciona como universidad en el contexto global y nacional, como una institución que se preocupa de la sostenibilidad”, destacó el rector de la casa de estudios, Carlos Torres Fuchslocher.
Este año la postulación estuvo centrada en iniciativas que incorporaran a estudiantes de pregrado. “Esto permite que desde temprano se hagan parte de estas instancias globales, vean los temas que están en boga y sean un factor de multiplicación de este conocimiento y estas experiencias con sus compañeros”, añadió la autoridad.
“Fue una excelente experiencia que nos permite crecer como futuros profesionales y nos posibilitó entender las nuevas tendencias para la mitigación del cambio climático”, expresó la integrante del equipo ganador, Camila Castro.
Por su parte, Francisco Escobar, señaló que, “fue una muy bonita experiencia, puede interactuar con muchas personas de muy diversos países y, además, conocí una serie de proyectos de otros lugares del mundo que pueden ser replicables en Chile”.
Fue la primera vez que la COP se desarrolló en una ciudad amazónica, siendo una instancia clave para negociar acuerdos sobre mitigación del cambio climático como parte de la Convención Marco de las Naciones Unidas sobre el Cambio Climático (CMNUCC).
Estudio microbiológico
Costras microbianas para el mejoramiento de suelos

Datos que aportan a la toma de decisiones
Académica y estudiantes están creando nuevas costras en base a las muestras que recolectaron en ambientes extremos.